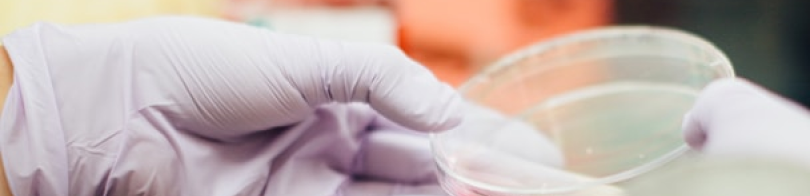

WHAT IS NABL ?

National Accreditation Board for Testing and Calibration Laboratories (NABL) is an accreditation body, with its accreditation system established in accordance with ISO/ IEC 17011. “Conformity Assessment –Requirements for Accreditation bodies accrediting conformity assessment bodies.” NABL provides voluntary accreditation services to:
Testing laboratories in accordance with ISO/ IEC 17025 ‘General Requirements for the Competence of Testing and Calibration Laboratories’ Calibration laboratories in accordance with ISO/ IEC 17025 ‘General Requirements for the Competence of Testing and Calibration Laboratories’ Medical testing laboratories in accordance with ISO 15189 ‘Medical laboratories -Requirements for quality and competence’ Proficiency Testing Providers (PTP) in accordance with ISO/IEC 17043 “Conformity assessment — General requirements for proficiency testing” and Reference material producers (RMP) in accordance with ISO 17034 “General requirements for the competence of reference material producers”.
NABL is Mutual Recognition Arrangements (MRA) signatory to ILAC as well as APAC for the accreditation of Testing and Calibration Laboratories (ISO/IEC 17025), Medical Testing Laboratories (ISO 15189), Proficiency Testing Providers (PTP) (ISO/IEC 17043) and Reference materials producers (RMP).












